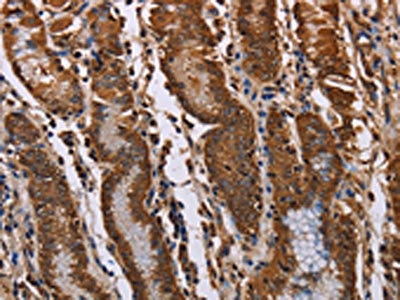

KIF2A Antibody
-
中文名稱:KIF2A兔多克隆抗體
-
貨號:CSB-PA786029
-
規(guī)格:¥1100
-
圖片:
-
The image on the left is immunohistochemistry of paraffin-embedded Human placenta tissue using CSB-PA786029(KIF2A Antibody) at dilution 1/70, on the right is treated with fusion protein. (Original magnification: ×200)
-
The image on the left is immunohistochemistry of paraffin-embedded Human gastric cancer tissue using CSB-PA786029(KIF2A Antibody) at dilution 1/70, on the right is treated with fusion protein. (Original magnification: ×200)
-
Gel: 6%SDS-PAGE, Lysate: 40 μg, Lane: Hela cells, Primary antibody: CSB-PA786029(KIF2A Antibody) at dilution 1/350, Secondary antibody: Goat anti rabbit IgG at 1/8000 dilution, Exposure time: 20 seconds
-
-
其他:
產(chǎn)品詳情
-
Uniprot No.:
-
基因名:KIF2A
-
別名:CDCBM3 antibody; HK2 antibody; KIF2 antibody; KIF2A antibody; KIF2A_HUMAN antibody; Kinesin 2 antibody; Kinesin heavy chain 2 antibody; Kinesin heavy chain member 2 antibody; Kinesin heavy chain member 2A antibody; Kinesin like protein KIF2A antibody; Kinesin-2 antibody; Kinesin-like protein KIF2A antibody; KNS2 antibody; M Kinesin antibody
-
宿主:Rabbit
-
反應(yīng)種屬:Human,Mouse,Rat
-
免疫原:Fusion protein of Human KIF2A
-
免疫原種屬:Homo sapiens (Human)
-
標(biāo)記方式:Non-conjugated
-
抗體亞型:IgG
-
純化方式:Antigen affinity purification
-
濃度:It differs from different batches. Please contact us to confirm it.
-
保存緩沖液:-20°C, pH7.4 PBS, 0.05% NaN3, 40% Glycerol
-
產(chǎn)品提供形式:Liquid
-
應(yīng)用范圍:ELISA,WB,IHC
-
推薦稀釋比:
Application Recommended Dilution ELISA 1:1000-1:2000 WB 1:200-1:1000 IHC 1:100-1:300 -
Protocols:
-
儲存條件:Upon receipt, store at -20°C or -80°C. Avoid repeated freeze.
-
貨期:Basically, we can dispatch the products out in 1-3 working days after receiving your orders. Delivery time maybe differs from different purchasing way or location, please kindly consult your local distributors for specific delivery time.
-
用途:For Research Use Only. Not for use in diagnostic or therapeutic procedures.
相關(guān)產(chǎn)品
靶點詳情
-
功能:Plus end-directed microtubule-dependent motor required for normal brain development. May regulate microtubule dynamics during axonal growth. Required for normal progression through mitosis. Required for normal congress of chromosomes at the metaphase plate. Required for normal spindle dynamics during mitosis. Promotes spindle turnover. Implicated in formation of bipolar mitotic spindles. Has microtubule depolymerization activity.
-
基因功能參考文獻:
- the crystal structure of a catalytically active kinesin-13 monomer (Kif2A) in complex with two bent alphabeta-tubulin heterodimers in a head-to-tail array, providing a view of these interactions, is reported. PMID: 29980677
- KIF2A expression was increased in human ovarian cancer patients and in tumor tissues and KIF2A mRNA contains two target sites for miR-206 binding and confirmed that miR-206 directly suppresses KIF2A; inhibits ovarian cancer cell proliferation, migration, and invasion; and induces apoptosis. PMID: 30352438
- Furthermore, silencing KIF2A inhibited cell proliferation and induced apoptosis in lung adenocarcinoma(LUAD) cells. In conclusion, KIF2A may serve as a valuable prognostic indicator and promising therapeutic target of LUAD. PMID: 29427669
- have identified a conserved WDR5 interaction (Win) motif, so far unique to the Mixed-lineage leukemia family PMID: 28633016
- The effect of Kif2A Knockdown on spreading could be rescued by expression of Kif2A-GFP or FLAG-AGAP1, but not by Kif2C-GFP. The results support the hypothesis that the Kif2A.AGAP1 complex contributes to control of cytoskeleton remodeling involved in cell movement. PMID: 27531749
- Study used high-resolution single-molecule microscopy to directly observe the stepping behavior of kinesin-1 and -2 family motors with different length neck-linker domains. Results provide a kinetic framework for explaining kinesin processivity and for mapping structural differences to functional differences in diverse kinesin isoforms. PMID: 28636917
- these data provide the first evidence that increased KIF2A expression predicts poor prognosis in patients with diffuse large B cell lymphoma, and a rationale for treatment of DLBCL by targeting KIF2A. PMID: 28616658
- The MuvB multiprotein complex, together with B-MYB and FOXM1 (MMB-FOXM1) regulate the expression of mitotic kinesins in breast cancer cells. PMID: 28061449
- Mdp3 (also known as MAP7D3) forms a complex with DDA3 (also known as PSRC1) and controls spindle dynamics at the minus end of Microtubuless by inhibiting DDA3-mediated Kif2a recruitment to the spindle. PMID: 27284004
- High KIF2A expression is associated with Gastric Cancer. PMID: 27773961
- KIF2A may be important in glioma progression. PMID: 26707290
- This study demonstrated colorectal cancer (CRC) tissue-preferred expression pattern of the KIF2A and suggested that high KIF2A expression might serve as an independent maker for poor prognosis in CRC patients. PMID: 26070867
- TTBK2 phosphorylates KIF2A and antagonizes KIF2A-induced depolymerization at microtubules plus ends for cell migration. PMID: 26323690
- Ras regulates KIF2A to control cell migration pathways in transformed human bronchial epithelial cells. PMID: 24240690
- KIF2A may play an important role in breast cancer progression and is potentially a novel predictive and prognostic marker for breast cancer. PMID: 24950762
- up-regulation of KIF2C and KIF2A by ERK1/2 caused aberrant lysosomal positioning and mTORC1 activity in a mutant K-Ras-dependent cancer and cancer model. PMID: 25002494
- Silencing Kif2a induces apoptosis and decreases the mRNA and protein level of PI3K, Akt and Bcell lymphoma 2 (Bcl2) in Tca8113 cells. PMID: 24248467
- The distribution of Kif2A was limited to the distal ends of the central spindle through Aurora B-dependent phosphorylation and exclusion from the spindle midzone. PMID: 23960144
- The kinesin-2 deficiency weakened intercellular adhesion, despite the maintenance of adherens junctions and other desmosome components at the plasma membrane. PMID: 22184201
- Data show that 4-oxo-4-HPR inhibited tubulin polymerization and modulated gene expression of spindle aberration associated genes Kif 1C, Kif 2A, Eg5, Tara, tankyrase-1, centractin, and TOGp. PMID: 19996280
- Kif2a has a role in bipolar spindle assembly along with MCAK PMID: 15302853
- Spindles in human mitotic cells depleted of the kinesin-13 proteins Kif2a and MCAK lack detectable flux and that such cells frequently fail to segregate all chromosomes appropriately at anaphase. PMID: 16243029
- KIF2 gene, located at 5q12.1, is a potential schizophrenia susceptibility gene PMID: 16959419
- kinesin-1, but not kinesin-2, contributes to the specific cytoplasmic distribution of three of the four steps of VV morphogenesis tested. PMID: 17394562
- These data demonstrate that Kif2b function is required for spindle assembly and chromosome movement and that the microtubule depolymerase activities of Kif2a, Kif2b, and MCAK fulfill distinct functions during mitosis in human cells. PMID: 17538014
- DDA3 interacts with the MT depolymerase Kif2a in an microtubule-dependent manner and recruits Kif2a to the mitotic spindle and spindle poles. PMID: 18411309
- Data show that Kif2a is regulated positively by Plk1 and negatively by Aurora A, and suggest that this antagonistic regulation confers differential stability to microtubules in the spindle versus at the pole versus in the cytosol. PMID: 19351716
顯示更多
收起更多
-
相關(guān)疾病:Cortical dysplasia, complex, with other brain malformations 3 (CDCBM3)
-
亞細(xì)胞定位:Cytoplasm. Cytoplasm, cytoskeleton, microtubule organizing center, centrosome. Cytoplasm, cytoskeleton, spindle pole. Cytoplasm, cytoskeleton, spindle. Note=Localized to the spindle microtubules and spindle poles from prophase to metaphase. Efficient targeting to spindle microtubules and spindle poles requires the kinase activity of PLK1. Recruited to mitotic spindles by interaction with PSRC1.
-
蛋白家族:TRAFAC class myosin-kinesin ATPase superfamily, Kinesin family, MCAK/KIF2 subfamily
-
數(shù)據(jù)庫鏈接:
Most popular with customers
-
-
YWHAB Recombinant Monoclonal Antibody
Applications: ELISA, WB, IHC, IF, FC
Species Reactivity: Human, Mouse, Rat
-
Phospho-YAP1 (S127) Recombinant Monoclonal Antibody
Applications: ELISA, WB, IHC
Species Reactivity: Human
-
-
-
-
-